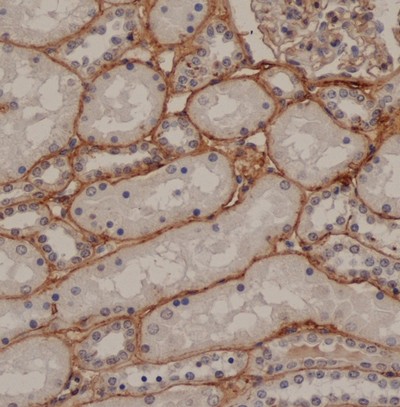

Fibronectin (FN1) (Matrix) Mouse Monoclonal Antibody [Clone ID: EP5]
Specifications
| Product Data | |
| Clone Name | EP5 |
| Applications | IHC |
| Recommended Dilution | Immunohistochemistry on Frozen Sections. Immunohistochemistry on Paraffin Embedded Sections: 1/25-1/100. Requires antigen retrieval using heat treatment prior to staining of paraffin sections. Sodium citrate buffer pH 6.0 is recommended for this purpose. |
| Reactivities | Human, Mouse |
| Host | Mouse |
| Isotype | IgG1 |
| Clonality | Monoclonal |
| Immunogen | Native Human Fibronectin (matrix) |
| Specificity | Recognizes Fibronectin specifically in connective tissues and vessels. No reactivity with the soluble dimeric form of Fibronectin (plasma Fibronectin), but highly reactive with matrix Fibronectin. Animal biodistribution experiments have shown that after intravenous administration, EP-5 antibody localizes to tumor vessels where it binds to the underlying basement membrane. At the same time the antigen recognized by EP-5 antibody is not accessible in normal tissue to circulating antibody indicating that this antibody can be used to target tumor vessels specifically in vivo. |
| Formulation | PBS State: Purified State: Liquid purified IgG fraction Preservative: 0.09% Sodium Azide |
| Concentration | lot specific |
| Purification | Affinity Chromatography on Protein A |
| Storage | Store undiluted at 2-8°C for one month or (in aliquots) at -20°C for longer. Avoid repeated freezing and thawing. |
| Stability | Shelf life: one year from despatch. |
| Database Link | |
| Background | Fibronectin is a glycoprotein present in a soluble dimeric form in plasma, and in a dimeric or multimeric form at the cell surface and in extracellular matrix. Fibronectin is involved in cell adhesion and migration processes including embryogenesis, wound healing, blood coagulation, host defense, and metastasis. They occur as dimers of two 250 kDa subunits. They have binding domains for bacterial proteins, collagens, heparin-like molecules and fibrin. Cellular fibronectin is widely distributed in the stroma of malignant tumours. Fibronectin is organized as a linear series of repeating modules which form domains for interaction with fibronectin itself, other matrix components (e.g. collagen and heparin) and receptors on cells (e.g. integrins). |
| Synonyms | FN1, Cold-insoluble globulin, CIG |
| Reference Data | |
Documents
| Product Manuals |
| FAQs |
{0} Product Review(s)
0 Product Review(s)
Submit review
Be the first one to submit a review
Product Citations
*Delivery time may vary from web posted schedule. Occasional delays may occur due to unforeseen
complexities in the preparation of your product. International customers may expect an additional 1-2 weeks
in shipping.






























































































































































































































































 Germany
Germany
 Japan
Japan
 United Kingdom
United Kingdom
 China
China